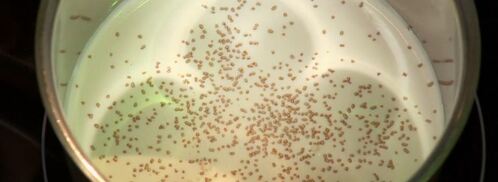
тунец в зеленом чае с фруктовым гарниром и сливочным соусом. Шаг 4

Тунец в зеленом чае с фруктовым гарниром и сливочным соусом
От: nadezhda92

Фото тунец в зеленом чае с фруктовым гарниром и сливочным соусом.
- Рецепт: Простой
- Время приготовления: 35 мин
- Порций: 4
- Калорий: 2325 ккал
- Кухня: Авторская
Состав:
- тунец — 150 г
- чай матча — 5 г
- манго — 1 шт.
- зерна граната — 50 г
- грейпфрут — 1 шт.
- груша — 1 шт.
- кинза — 50 г
- помидоры черри — 70 г
- сливки — 100 мл
- сыр пармезан — 70 г
- салат латук — 5 г
- бульон рыбный
- масло кунжутное
- масло оливковое
- розовый перец молотый
- черный перец
- соль
Как приготовить
-
Посолим, поперчим филе тунца. Панируем в чае матча. Обжариваем на сковороде с добавлением оливкового масла. Выкладываем на бумажную салфетку, чтобы убрать лишнее масло.
-
2. Очищаем манго от кожуры и нарезаем кубиком. Добавляем зерна граната, нарезанные мякоть грейпфрута и грушу. Посыпаем кинзой. Перемешиваем. Посолим, поперчим. Добавляем кунжутное масло.

-
3. Надрезаем помидоры черри на ветке. Посолим, поперчим. Добавляем оливковое масло. Обжариваем помидоры на сковороде с добавлением оливкового масла.

-
4. Наливаем сливки в сотейник. Добавляем сухой рыбный бульон и перец. Доводим до кипения. Добавляем чай матча и тертый сыр пармезан.

-
5. Нарезаем тунец ломтиками. Украшаем соусом тарелку. Выкладываем тунец на соус. Добавляем помидоры черри и салат. Украшаем салатом латук, соусом и розовым перцем. Приятного аппетита!

Обсуждение
Nadezhda92, это очень вкусно !!!!!!!!! спасибо!:)
Боже мой как просто, а как вкусно, оценили все, теперь это мое дежурное блюдо!!!
Очень рада что нашла этот сайт!!!
Все понятно)
nadezhda92, спасибо большое!!!)
Скумбрия под пикантным соусом arcept.ru/goryachee/ryba/skumbriya-pod-pikantnym-sousom тоже интересный вариант.
Очень, очень, очень вкусно!!!
Вкусная штука :)
Постараюсь приготовить в ближайшее время.
Сделала это блюдо впервые, получилось.
Спасибо вам Большое!!!